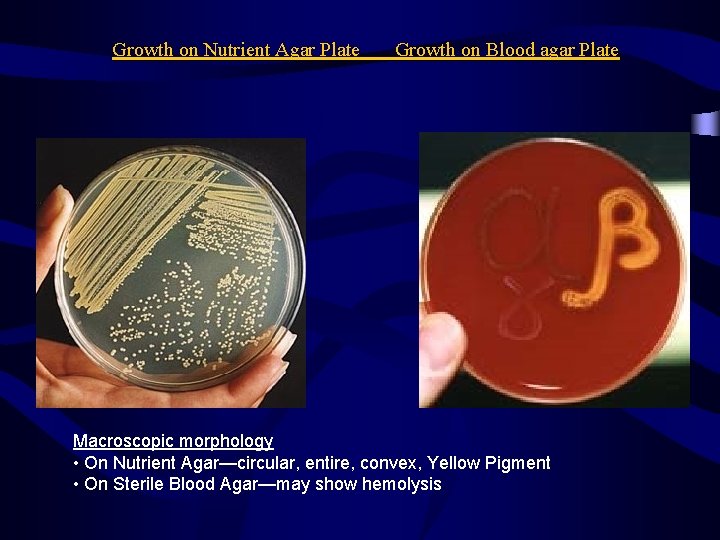
Growth on Nutrient Agar Plate Growth on Blood agar Plate Macroscopic morphology • On
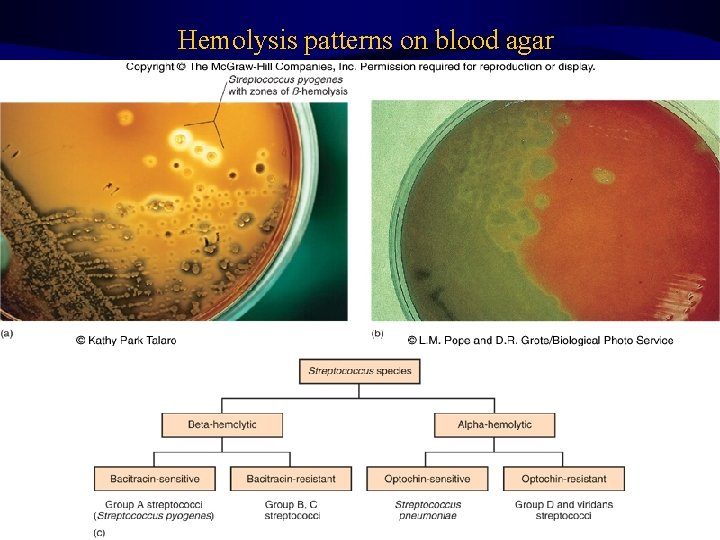
Hemolysis patterns on blood agar 34

Skin Infections MSS Module By Dr Amin A

Skin Infections MSS Module By Dr. Amin A. Aqel Associate Prof. of Medical Microbiology Faculty of Medicine, Mutah University

Outlines • Anatomy and physiology • Normal flora of skin • Bacterial skin diseases • Viral skin diseases

Bacterial Infection of Skin The Skin Definition Skin is largest organ of body Maintains homeostasis, protects underlying tissues and organs, protects body from mechanical injury, damaging substances, and ultraviolet rays of sun. – Factors controlling the skins microbial load ? !!

Skin Structure

Anatomy and Physiology • If skin is intact, it is remarkably resistant to infection. • Skin injuries such as cuts, punctures, burns, chemical injury, hypersensitivity reactions and insect bites allow pathogen entry which may infect skin and underlying tissues. • Skin infections may also occur through blood infections and or toxin production.

Bacterial Infection of Skin Unbroken skin prevents entrance of bacteria.

Bacterial Infection of Skin Broken skin allows Bacteria to enter Trauma, Wound, puncture, Accident, etc.

Normal flora of skin • Classification: 1. Resident flora: grow on skin & relatively stable in number and composition at particular sites 2. Transient flora: lie on skin surface without attachment, unable to multiply & disappear within short time

Normal Skin Flora • Large numbers of microbes live on or in the various components of the normal skin depending upon the body location and amount of skin moisture. • The number of bacteria may range 1000 organisms/cm 2 on the back to more than 10 million in the groin and armpit where moisture is more. • Skin microbes are opportunistic pathogens. Diphtheroids are responsible for body odor, caused by breakdown of substances in the sweat.

Staphylococcus species • • • Staph: grape-like clusters coccus: spherical Gram-positive bacteria - 0. 5 -1. 5 m in diameter All are catalase positive All pathogenic S. aureus are coagulase positive Coagulase negative staphylococci: – S. epidermidis – S. saprophyticus – Others

Charactristics of Staphylococci • Colonial morphology: Colonies are grey to golden yellow and produces hemolysins (beta hemolysis on Blood Agar). • Salt-tolerant organisms and grow well on salty skin surface. • They can cause serious disease if host defenses are impaired. • Staphylococci are the most common skin bacteria and grow aerobically. Principle species is Staphylococcus epidermidis. • Important function of skin’s staphylococci are to prevent colonization by pathogens and to maintain a balance among the microbial inhabitants of the skin ecosystem.

• STAPHYLOCOCCAL INFECTIONS – – – Skin and soft tissue: Folliculitis, Furuncle (boil), carbuncle, impetigo, Abscess (particularly breast abscess), wound infection, paronchia, less often cellulitis Food poisoning, SSS and TSS S. epidermidis are novobiocin- sensitive and can cause endocarditis and may cause infections on top of prosthetic devices e. g. prosthetic valves or artificial joints. – S. saprophyticus can cause urinary tract infections. – Musculoskeletal: • Osteomyelitis, arthritis, pyomyositis.

Epidemiology • S. aureus inhabits the nostrils of virtually everyone. Moist areas of skin are also frequently colonized. • People with boils and other staphylococcal infections shed large number of S. aureus and should not work with food, or near patients with surgical wounds or chronic illnesses. 2 - Transmission: a) Via droplets (sneezing) and skin scales (hands) b) Direct contamination of surgical wounds c) Contaminated foods: e. x. Ham, canned meats, custard pastries, and potato salad.


Bacterial skin infections Staphylococcus aureus 1 - Focal suppuration and abscess formation 2 - Toxigenic staphylococcal diseases 1 - Focal suppuration and abscess formation This is due to coagulase, infections include: – Folliculitis and Boils (furuncles) – Carbuncles are larger and deeper than boils – Abscesses – Outbreaks of hospital acquired wound infections commonly occur due to antibiotic resistant staphylococci.

Folliculitis • Minor infection of hair follicles • Commonly caused by S. aureus, P. aeruginosa • Scalp, limb, face, neck and buttocks. • Rarely painful • Heals in a week


Furuncle (Boil) • Acute Superficial skin infection result from S. aureus invasion of hair follicles making small abscess • It may develop also in a sebaceous or sweat gland. • 2 -4 days, folliculitis, fibrin deposit, site walled off. • Small, follicular noduler -- Pustule--necrotic--discharge pus • Painful • Heals with scar • Site: Neck, Wrist, Waist, Buttocks, Face


Carbuncle • S. aureus • Extensive infection of a group of contagious follicles, dermis and subcutaneous tissues. • Extensive multilocated abscesses. • Middle or old age • Predisposing factors – Diabetes – Malnutrition – Severe generalized dermatoses – During prolonged steroid therapy

Carbuncle • Painful, hard lump • Suppuration begins after 5 -7 days • Pus discharge from multiple follicular orifices • Necrosis of intervening skin • Large deep ulcer

Carbuncle

Staphylococcal skin infections 2 - Toxigenic staphylococcal diseases: – Food poisoning – Toxic shock syndrome (TSS): • TSST-1 • There is septicemia and toxemia • TSS has an abrupt onset of fever, vomiting, diarrhea , muscle pains and rash. Hypotension , heart failure and renal failure may occur in severe cases. • skin manifestations include a rash followed by desquamation of the skin, particularly soles and palms • Scalded skin syndrome (Ritter’s or Lyell’s disease): • Exfoliative toxin • The syndrome occurs in babies and young children • Characterized by large areas of desquamation of the skin and generalized bulla formation due to destruction of the intercellular connection.

Staphyococcocal Scalded Skin Syndrome (SSSS) • About 5% of S. aureus strains Produce exfoliatins. • The disease can appear in any age group but occurs most frequently in new born infants, the elderly, and immunocompromized adults.


Acne: Propionibacterium acnes • Most P. acnes strains are anaerobic and grows primarily in the hair follicles. Some strains are aerotolerant. Gram positive rods. • Most common skin disease in humans • Inflammation of hair follicles and sebaceous glands. • Oil-based cosmetics worsen disease • No effects of diet • Its lipase contributes to the genesis of acne • Black heads • Growth of P. acnes is enhanced by the oily secretion of sebaceous glands and are present in areas like face, upper chest, and back.

Diabetic Foot Infection • Organisms: – skin organisms: S. aureus, -hemolytic strep, diphtheroids – Gram-negative bacilli (E. coli, K. pneumoniae, Pseudomonas spp. ) – Anaerobes • Cellulitis>Deep soft tissue infection>Osteomyelitis • Risk factors: – vascular disease (macro and micro) – peripheral neuropathy – poor foot care

Bone Infections • Osteomyelitis – infection of the bone – hematogenous or contiguous – S. aureus, S. pyogenes, – H. influenzae, Gram-negative bacilli • Septic arthritis – infection of joint spaces – hematogenous or contiguous – S. aureus, Streptococcus spp. , – Gram-negative bacilli

Break


Streptococcus species • • Strepto: chain-like coccus: spherical Gram-positive bacteria - 0. 5 -1. 5 m in diameter White to grey colonies of various sizes on blood agar Non-spore-forming, nonmotile Can form capsules and slime layers Facultative anaerobes Sensitive to drying, heat, and disinfectants • Tissue digesting enzymes – Hyaluronidase – Streptokinase – Streptolysins

Streptococci • Lancefield classification system based on cell wall Ag – Ccarbohydrate (A, B, C, …. U) • Another classification system is based on hemolysis reactions – -hemolytic: partial hemolysis of RBCs • viridans streptococci, Streptococcus pneumoniae – -hemolytic: complete hemolysis of RBCs • Streptococcus pyogenes, Streptococcus agalactiae – -hemolytic: no hemolysis of RBCs • some Streptococcus milleri 32
Growth on Nutrient Agar Plate Growth on Blood agar Plate Macroscopic morphology • On Nutrient Agar—circular, entire, convex, Yellow Pigment • On Sterile Blood Agar—may show hemolysis
Hemolysis patterns on blood agar 34

• STREPTOCOCCAL INFECTIONS (Pyogenic infections with a tendency to spread locally, along lymphatic's and through blood stream) Skin and soft tissue: • Impetigo • Erysipelas • Infections of the wounds or burns, cellulitis, Infection of minor abrasions may lead to fatal septicemia • Diseases: - infections ranging from pharyngitis and cellulites to sepsis. they can trigger immunologic disorder like rheumatic fever or acute glomerulonephritis

Impetigo (Pyoderma) A skin infection characterized by pus production is called Pyoderma. • Impetigo is the most common type of pyoderma. Symptoms • Impetigo is a superficial skin infection and involves patches of epidermis. • Thin-walled blisters develops and then break, and they are replaced by yellowish crusts (formed from the drying plasma that weeps through the skin). • Usually little fever or pain and lymph nodes enlargement Causative agents: • Staphylococcus aureus often causes impetigo but many cases, even epidemics, are caused by Streptococcus pyogenes.

Pictures (Step 1) (Step 2) (Step 3)

Prevention • Regular hand washing – baths or showers regularly Contagiousness!!!! !! • Infected skin or other items – Clothing, towels, and bed linens

Erysipelas Rapidly spreading painful bacterial infection of the deeper layers of the dermis with sharply well-defined raised border. blocking of dermal lymphatics and presents as well –defined spreading, edematous erythematous inflammation generally on the face (butterfly distribution on the cheeks and bridge of the nose), legs, feet and often accompanied by pain, fever and lymphadenopathy. Septicemia or local skin necrosis may occur Caused by group A beta haemolytic streptococci (Streptococcus pyogenes)

Cellulitis • Usually acute inflammation of subcutaneous connective tissue • Streptococcus pyogenes, or GAS, S. aureus, H. influenzae b, gram-negative rods, clostridia and other anaerobes. • Erythematous, edematous, swelling with Pain/tenderness • Cellulitis can exist alone, with no pus, or it can surround an area of pus. • Constitutional upset

Cellulitis Features: Red Swollen Warm to touch No areas of pus Painful Cellulitis Tender

Necrotizing Fasciitis “Flesh Eating Strep” Streptococcus pyogenes (Group A Strep) – sever infection involving the subcutaneous soft tissue, particularly the superficial and deep fascia – predisposing conditions: diabetes, abdominal surgery, perineal infection, trauma – organisms: S. pyogenes, C. perfringens, mixed aerobic and anaerobic bacteria • Incidence 1 -20/100, 000 • 30 -70% mortality

Indications of Necrotizing Fasciitis • Patients deteriorate rapidly and frequently die • If the area of redness is spreading rapidly (this means about ½ inch or more per hour) this may be “Necrotizing Fasciitis” • If the area is extremely painful • If the person shows signs of bacteria getting into the bloodstream (fever, change in mental function such as delirium, profound weakness) • Draw a line around the red area with a pen, then watch for spreading beyond the line

Cellulitis with abscess If rapid spreading beyond this line occurs, this may be necrotizing fasciitis, and requires surgery

Treatment of Necrotizing Fasciitis • Cut all the dead tissue out, and keep cutting until only living tissue is left • Go back and do the same thing every few hours, as often as necessary, until the infection stops spreading • Antibiotics help, but they will NOT cure the infection • Without appropriate, drastic surgery the person will die • The open muscle is then treated like a burn, with skin grafts

Necrotizing fasciitis

Necrotizing fasciitis after debridment

Hansen’s Disease: Leprosy Mycobacterium leprae • Disease of skin and nerves • Change of pigmentation, loss of sensation • Slow progressing • Transmits poorly • Droplet or skin contact? • Mycobacterium leprae • Acid fast bacterium

Paronychia • Infection of the subcutaneous tissues around the nails • can present as an acute or chronic lesion. • Acut: Staph aureus and Strep. pyogenes. Herpes simplex virus can also cause paronchia. • Chronic paronychia, involving the loss of the cuticle. Gramnegative bacilli, such as E coli, Pseudomonas aeruginosa, Proteus mirabilis, Bacteroids fragilis and yeasts. Candida albicans are the usual causative organisms.

Other skin infections • Wound infections: surgical, traumatic or physiologic. – Clean wounds – Clean contaminated wounds – Contaminated wounds – Dirty and infected wounds • Burns (P. aeruginosa) • Human and Animal bites

Bacterial Infection of Skin Lab. Diagnosis specimen collection. 1. Skin biopsy 2. Skin swab 3. Scrapes the base of the lesion with a swab.

Laboratory diagnosis 1 - Gram stain 2 - Culture: Blood Agar, Mannitol Salt Agar 3 - Biochemical tests: Coagulase (+), heat-stable nuclease (+), mannitol fermentation and Catalase test • Isolated colonies are further identified by: – Phage typing is used for epidemiologic tracing of “outbreaks of wound infections” in hospitals. • Molecular and Immunological detection.

Bacterial Infection of Skin

References • Sherris, Medical Microbiology: an introduction to infectious diseases, by Ryan and Ray, fourth edition, Mc Graw Hill, 2004 • Medical Microbiology, by Mims, second edition, Mosby, 1998
- Slides: 54